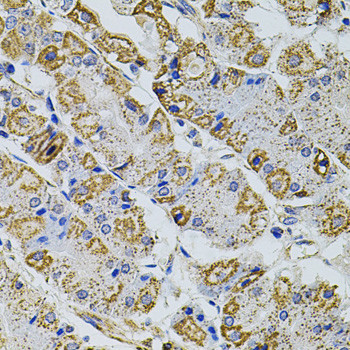
PRAMEF20 Antibody in Immunohistochemistry (Paraffin) (IHC (P))

Search
Invitrogen
PRAMEF20 Polyclonal Antibody
{{$productOrderCtrl.translations['antibody.pdp.commerceCard.promotion.promotions']}}
{{$productOrderCtrl.translations['antibody.pdp.commerceCard.promotion.viewpromo']}}
{{$productOrderCtrl.translations['antibody.pdp.commerceCard.promotion.promocode']}}: {{promo.promoCode}} {{promo.promoTitle}} {{promo.promoDescription}}. {{$productOrderCtrl.translations['antibody.pdp.commerceCard.promotion.learnmore']}}
图: 1 / 4
PRAMEF20 Antibody (PA5-109772) in IHC (P)




Please note: We are reviewing Western blot images included in the antibody testing data in our catalog, including those provided by third parties. Unless expressly labeled or annotated as “raw-unedited”, Western blot images included in the antibody testing data in our catalog may have been edited, optimized or otherwise adjusted for presentation.
产品信息
PA5-109772
种属反应
宿主/亚型
分类
类型
抗原
偶联物
形式
浓度
规格
纯化类型
保存液
内含物
保存条件
运输条件
RRID
产品详细信息
Immunogen sequence: MSSKPLLTLQ ELAAQNILRN EALAISALQY LPELFLPQLL KQAYDGNHLK VLRAIVSSWP FPRLPLGALK KRTPYLETQL QVVLEEVDKL LIQEVHPREY KLEVLDLRSV GQNYLNVWPG AMDDWLPKTT QTDPCCSKTV MTQPLKVLVD LQLNNRGQSR LFSYLVQWSD RRKGLLQLYC NKLQIWSPSQ QNYRKLSQKV NLDYVETLGL HSSCSPSFLL NFAPYLRQMR NLRKLALSNI REEHIISPEK RRCIITRFTL QILKLESLQK LHLDAVCFLE GHLDQLLGSV KTSLDELAVT HCNLSVSEWS HFSEFPCVSQ LQQLNLENVR LTGLSPEPLQ VLLVKAGPTL VALDLEDCHL EDGQLYAILP ALSKCFKLTK FSFYGNQISM LAMKDLLHHT ASLIHLRLEL YPVPQDSYDY HGTPLMQRMQ QHCDELMNLL KTFRNPGRVF FGTDRCDQCC NRYIYNKTIM CNCRRSY
仅用于科研。不用于诊断过程。未经明确授权不得转售。
篇参考文献 (0)
生物信息学
蛋白别名: novel preferentially expressed antigen in melanoma (Prame) protein; PRAME family member 20; PRAME family member 25-like; preferentially expressed antigen in melanoma-like 1-like
基因别名: EG627009; OTTMUSG00000010547; PRAMEF20; PRAMEF21; pramef25
Entrez Gene ID: (Mouse) 627009, (Rat) 691150